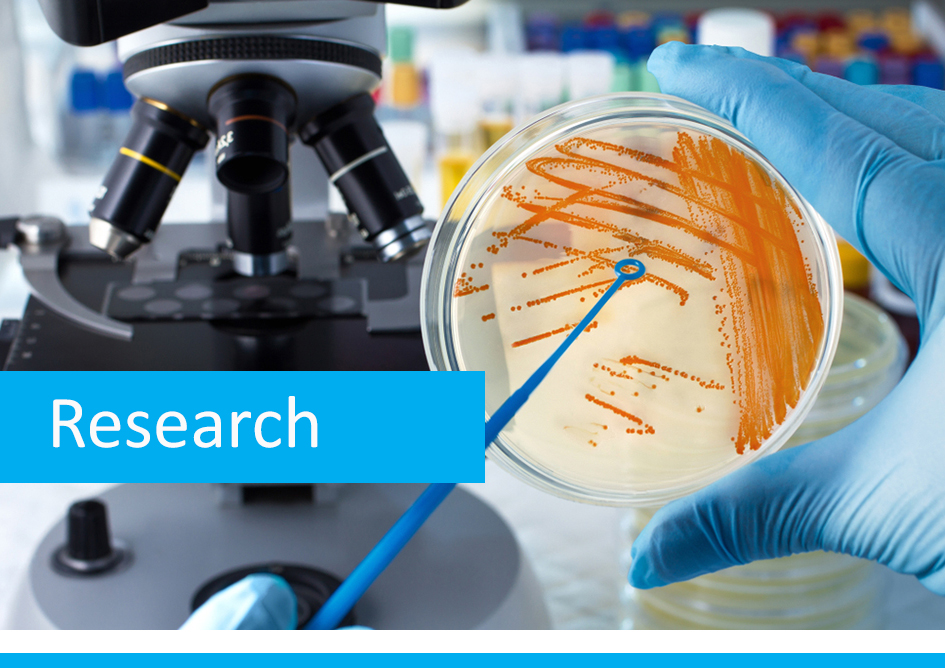

Welcome to the pages of the Faculty of Natural Sciences!
The Faculty of Natural Sciences in Pula (FPZ) is the foundation of development of natural and environmental sciences at the University. The scientific work of our experts and collaborators, oriented toward research of biodiversity and processes in the Adriatic Sea, human impact on marine ecosystems and finding new approaches in conservation and management of marine biological resources, forms the basis of our undergraduate university study programme Marine Science.
Pristupačnost